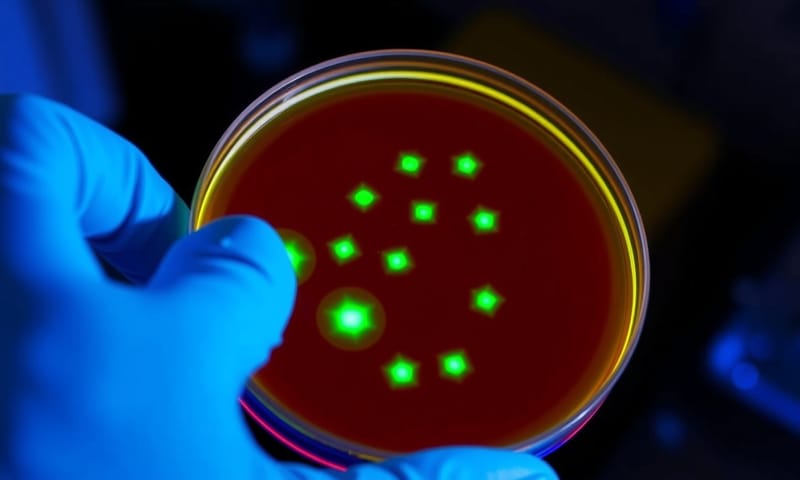
實驗室篩選：帶有螢光標記基因的細菌在紫外線下發光

細菌其實是超強的迷你工廠?
今天來聊聊生物科技,喔不是,講得更白話一點,就是怎麼「駭進」細菌的系統,讓它們從單純的微生物,變成我們專屬的迷你生產線。聽起來很像科幻片對吧?但這件事早就發生了,而且可能你吃的、用的、甚至救命的藥,都跟這有關。
我自己是覺得,這整件事的核心概念很簡單:我們學會了細菌的「語言」— 也就是DNA — 然後用這個語言去下指令,叫它們幫我們做事。超酷。
先說結論:根本是生技界的工業革命
簡單講,就是把一段有用的基因(例如製造胰島素的基因),像裝App一樣「安裝」到細菌體內。然後利用細菌超快的繁殖能力,短時間內大量複製這個基因,順便生產出我們想要的東西。這比傳統方法快太多,也精準太多了。從救命的藥到更環保的材料,應用範圍真的很廣。
不信?看看這幾個已經改變世界的例子
光說很抽象,直接看案例最快。這不是什麼未來科技,是現在進行式。
第一個,也是最經典的,就是胰島素。在基因工程出現以前,糖尿病患者用的胰島素是從豬或牛身上提煉的。嗯...你想想,除了成本高,還可能引起一些人的過敏反應,畢竟不是百分之百的人類版本。後來科學家就想到,欸,不如我們讓細菌來做?
他們把製造人類胰島素的那段基因,從人類DNA中找出來,然後植入常見的大腸桿菌 [E. coli] 裡。結果呢?這些被「改造」過的大腸桿菌,就變成了超高效率的胰島素工廠,生產出來的胰島素跟人體的一模一樣。這直接改變了全球上億糖尿病患者的生活,說它是救命等級的發明,一點都不誇張。

再來是農業上的應用,也就是大家常聽到但可能有點怕怕的「基因改造作物」[GMOs]。例如有一種叫做Bt棉花的,科學家把蘇力菌 [Bacillus thuringiensis] 裡面一個會產生天然殺蟲蛋白的基因,放進棉花裡。結果就是,這種棉花自己就能抵抗某些害蟲,農夫就可以大幅減少農藥的使用。對環境、對農夫的健康,理論上都是好事。
還有一個例子叫「黃金米」[Golden Rice],這種米被植入了可以製造胡蘿蔔素(維生素A的前驅物)的基因。這不是為了讓它更好吃或更好看,而是為了要解決開發中國家嚴重的維生素A缺乏問題,那可是會導致兒童失明甚至死亡的。所以你看,很多基因改造的初衷,其實是為了解決很實際的生存問題。
所以...這到底是怎麼做到的?
好,看了這麼多神奇的應用,你一定會好奇,科學家到底怎麼把A生物的基因,裝到B生物(通常是細菌)裡面去的?過程其實蠻聰明的,有點像在做分子等級的樂高。
首先,你要有個「交通工具」,負責把你要的基因載進細菌體內。這個交通工具就是細菌體內本來就有的東西,叫做「質體」[plasmids]。你可以把質體想像成一個小小的、環狀的DNA,像個USB隨身碟,它在細菌的主要染色體之外獨立存在,而且可以自己複製。
有了隨身碟,你還需要「剪刀」跟「膠水」。
- 剪刀:這就是「限制酶」[restriction enzymes]。它超酷的地方是,它只會辨識DNA序列中特定的點,然後「喀嚓」一聲剪開。不同的限制酶會認不同的序列,像是有很多把功能不同的精密剪刀。
- 膠水:這個叫「DNA連接酶」[DNA ligase]。它的工作很單純,就是把斷開的DNA片段重新黏合起來。
有了這些工具,整個流程大概是這樣:
- 目標鎖定:先從來源生物(比如人類)的細胞裡,把我們想要的那段基因(比如胰島素基因)找出來並分離。
- 剪貼作業:用「同一把」限制酶,去剪我們的目標基因,也去剪細菌的質體。這樣兩邊就會產生可以完美互補的「切口」。
- 組合:把目標基因跟被剪開的質體混在一起,然後加入DNA連接酶這個膠水,把基因「貼」進質體裡。這樣,一個全新的「重組質體」就誕生了。
- 轉入細菌:接下來是最關鍵的一步,把這些重組質體送回細菌裡。這個過程叫做「轉形」[Transformation]。科學家會用一些方法(比如電擊或化學處理)讓細菌的細胞膜暫時出現小洞,好讓質體跑進去。
- 篩選和培養:當然,不是每個細菌都會成功接收到新的質體。所以科學家通常會在質體上多放一個「標記」,例如抗生素抗性基因。接著,他們就把所有細菌養在含有那種抗生素的培養皿上。結果很明顯:沒有成功轉形的細菌會死光,只有那些成功帶著新質體(以及抗藥性基因)的細菌能活下來。
- 開始生產:最後,把這些篩選出來的「超級細菌」放進大型發酵槽裡,提供足夠的養分讓它們瘋狂繁殖。在這個過程中,它們就會不斷地讀取我們植入的基因,並製造出我們想要的蛋白質(例如胰島素),我們再把這些產物收集純化就好。
基因工程跟傳統育種,到底差在哪?
說到改造生物,很多人會想到傳統的育種,像是把比較甜的橘子跟比較多汁的橘子拿去雜交,希望能得到又甜又多汁的下一代。那基因工程跟這個差在哪?我自己是覺得,這根本是不同維度的東西。
| 比較項目 | 傳統育種 | 基因工程 |
|---|---|---|
| 速度 | 超...級...慢...。一個品種可能要搞個幾年甚至幾十年。完全是看天吃飯。 | 快狠準。理論上幾個月內就能看到結果。直接從分子層級動手。 |
| 精準度 | 很低,像在攪拌一鍋湯。你想要A性狀,結果常常會順便把B、C、D不想要的性狀也一起遺傳過去。 | 極高。就像用鑷子,精準地夾取或放入你想要的那一小段基因,不太會動到其他地方。 |
| 範圍 | 限制很大,基本上只能在可以自然交配的「近親」物種之間進行。你總不能讓番茄跟魚雜交吧。 | 幾乎沒有限制。DNA的語言是共通的,所以可以把魚的基因放進番茄,或把人的基因放進細菌。這點最猛,但也最引發爭議。 |
| 結果可預測性 | 一半一半吧。很多時候是隨機組合,能不能得到想要的結果,要靠運氣跟大量的篩選。 | 高度可預測。只要你的設計是對的,理論上製造出來的生物就會帶有你預期的性狀。 |
不只醫藥和農業,還有更多你想不到的用途
除了前面說的胰島素和GMO,這技術的應用範圍其實越來越廣。
例如在工業上,很多洗衣粉裡面的酵素,就是用基因改造過的微生物生產的,可以更有效分解油污。還有科學家正在研究用細菌來生產「生物可降解塑膠」[Biodegradable Plastics],希望能取代一些石化塑膠。甚至還有用來製造生質燃料的,希望能成為新的能源選項。
還有一個我覺得超有潛力的領域,叫做「生物修復」[Bioremediation]。簡單說,就是派出經過基因改造的細菌大軍,去「吃掉」環境中的污染物。例如,有些細菌被改造成可以分解漏油事件中的原油,或是吸收工廠廢水裡的重金屬。這簡直就是把清道夫的功能升級了好幾個檔次。

當然,這技術不是沒有風險和爭議
聊了這麼多好處,也要平衡一下,談談大家最擔心的部分。這東西這麼強大,一定有它的風險和道德爭議。
最常見的疑慮就是安全。基因改造生物會不會跑到野外,破壞原本的生態平衡?吃GMO食物,長期下來對人體有沒有未知的影響?這些都是很合理的問題。目前主流科學界的看法是,沒有證據顯示通過審查上市的GMO食品比傳統食品更危險。但重點是「通過審查」,所以嚴格的法規和監管就很重要。
說到監管,各國的作法很不一樣。這點我覺得蠻有趣的,可以拿美國跟台灣來比對一下。在美國,FDA(食品藥物管理局)對於GMO食品的標示相對寬鬆,很多時候是採取自願標示。但在台灣,我們的《食品安全衛生管理法》就嚴格很多,規定只要食品含有基因改造成分,不論是多是少,都必須在包裝上強制標示「基因改造」或「含基因改造」的字樣。這沒有絕對的對錯,反映了不同社會對於消費者「知情權」的重視程度不同。
再來就是更深層的倫理問題了。如果基因編輯技術(特別是像更進階的 CRISPR-Cas9)可以用在人類身上,我們要畫一條什麼樣的底線?修復致命的遺傳疾病,大家可能都贊成。但如果拿來「增強」智力或外貌呢?這會不會製造出「訂製寶寶」[designer babies],加劇社會不平等?這問題已經超出了科學的範疇,是整個社會需要一起思考的哲學問題。
未來呢?CRISPR 會讓一切變得更瘋狂
如果說前面講的技術像是用剪刀和膠水,那現在最紅的 CRISPR-Cas9 技術,就比較像是文書處理軟體裡的「尋找與取代」功能。它的精準度、效率和成本,都跟傳統的基因工程不在一個數量級上。
這代表基因編輯的門檻大幅降低了。以前可能只有頂尖的大型研究中心玩得起,現在很多小型實驗室都能做。這當然會加速各種應用的開發,但也可能讓監管變得更困難。這項技術的潛力真的很大,從根治遺傳病、開發新藥,到解決糧食危機,但伴隨而來的挑戰也同樣巨大。
總之,生物科技這扇門已經打開了。我們學會了怎麼對生命最底層的程式碼進行讀寫,接下來怎麼用好這份力量,真的考驗著全人類的智慧。你覺得呢?如果這項技術完全成熟且安全,你最希望用它來解決什麼問題?是治療疾病、對抗氣候變遷,還是有其他更有趣的想法?



